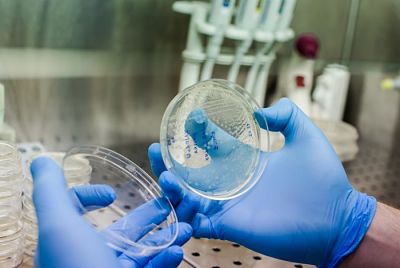

Fármaco plitidepsina logró reducir el 99% de la carga viral del covid-19 en pruebas de laboratorio
Un fármaco antiviral (la plitidepsina), producido por la empresa española Pharmamar y probado en laboratorios experimentales de Francia y Estados Unidos, demostró una disminución del 99% de las cargas virales del SARS-CoV-2.
Los experimentos “in vitro” e “in vivo” que se realizaron en modelos animales con este fármaco, utilizado como antitumoral, demostraron una eficacia antiviral y un perfil de toxicidad prometedores, informó este martes la farmacéutica española tras la publicación de los resultados en la revista Science.
Los autores concluyeron que la plitidepsina es “con diferencia” el compuesto más potente descubierto hasta ahora y plantearon que debería probarse en ensayos clínicos ampliados para el tratamiento de la enfermedad de COVID-19.
El trabajo es fruto de la colaboración entre la española PharmaMar y los laboratorios de los investigadores Kris White, Adolfo García-Sastre y Thomas Zwaka, en los Departamentos de Microbiología y de Biología Celular, Regenerativa y del Desarrollo, en la Icahn School of Medicine del Mount Sinai (Nueva York); de
...Es eficaz la combinación de Sputnik V y AstraZeneca, según resultados preliminares de un estudio en El Día
La ivermectina tendría un efecto antiviral en pacientes con COVID-19, según un estudio argentino en Los Tiempos
EEUU invertirá $us 3.200 millones en píldoras contra el Coronavirus en El Día
Crean en China embriones mezcla de mono y humano en El Día
Prueba de cuatro nuevos tratamientos contra covid-19 en El Diario
Vacuna de una sola dosis puede aliviar la escasez en El Día
El estudio europeo Discovery dejó de estudiar al fármaco remdesivir por falta de eficacia en El Día
Una dosis de vacuna podría ser efectiva contra Covid-19 en El Diario
